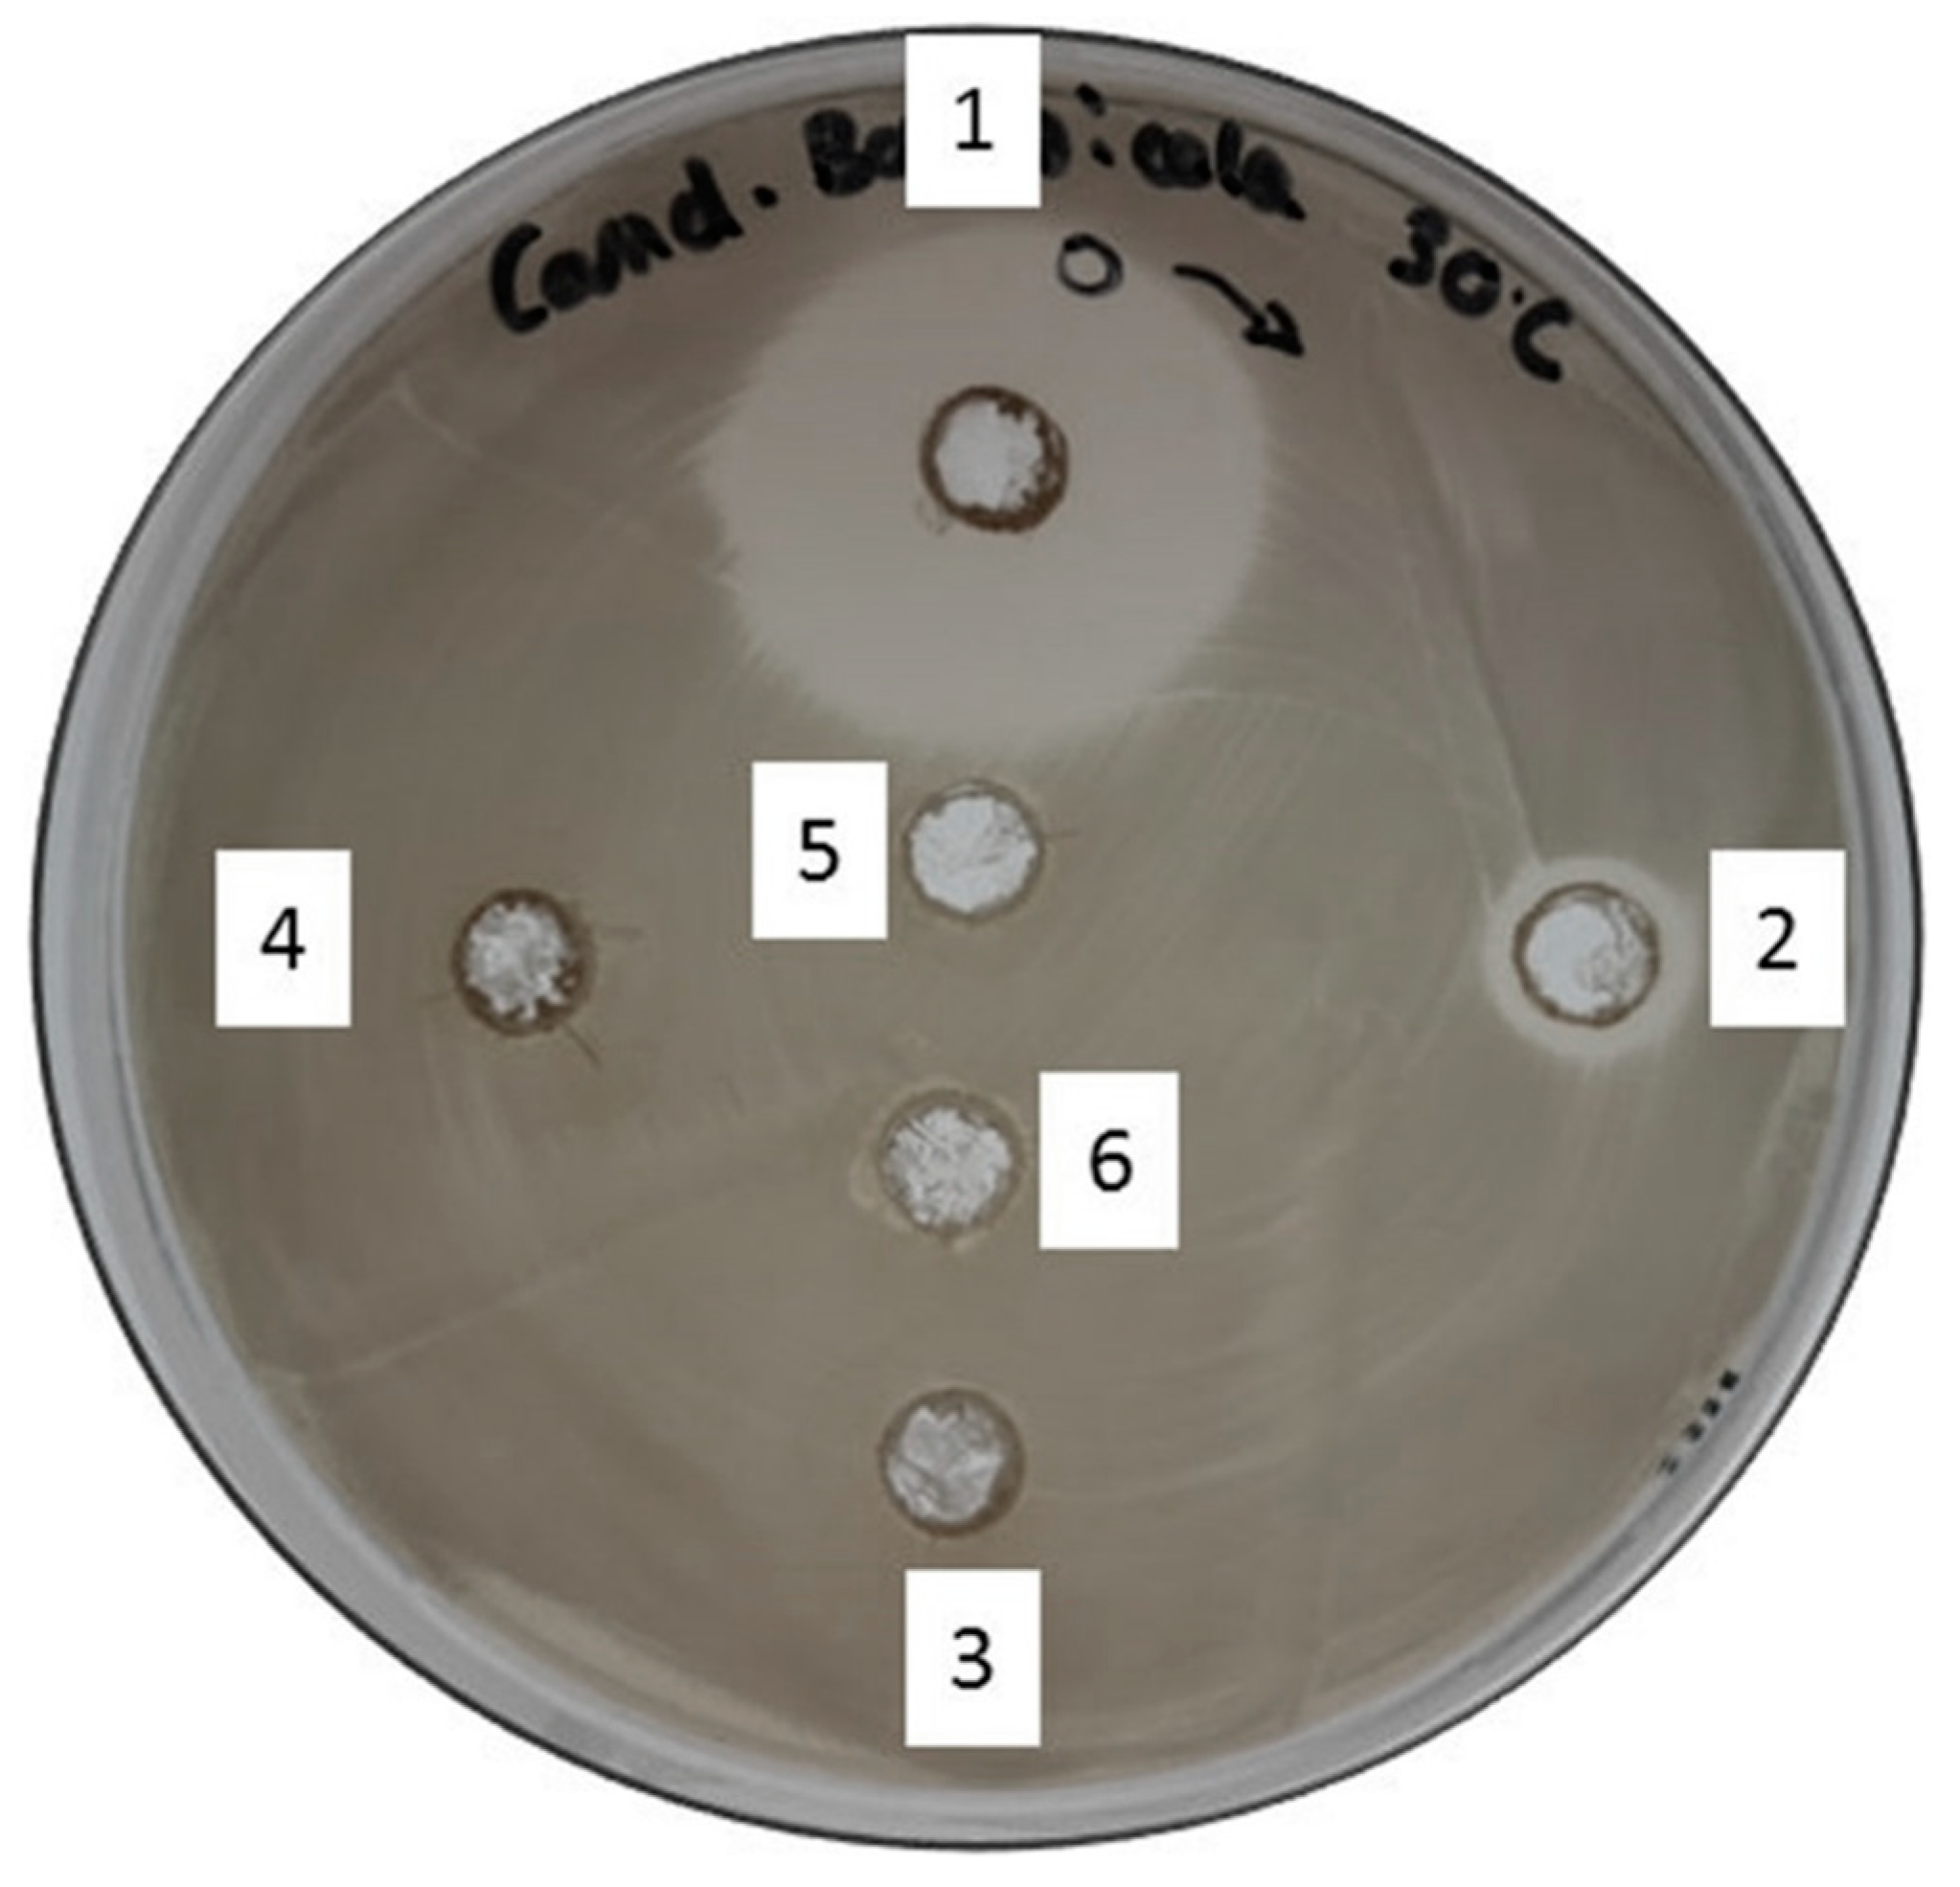
Ijms 23 12031 g003

Enhanced Bioactivity of Tailor-Made Glycolipid Enriched Manuka Honey
Abstract
1. Introduction
2. Results
2.1. Glycolipid Synthesis in Honey
2.2. Microorganisms Susceptibility Test
2.3. Whole-Cell Multi-Stress Biosensing and Bactericidal Activity in Broth Dilution
2.4. Bactericidal Activity Assay on Agar Plate
3. Discussion
3.1. Impact of the Process on Endogenous and Exogenous Compound in Manuka Honey
3.2. Role of the Glycolipids in Bioactivity Enhancement
4. Materials and Methods
4.1. Materials
4.1.1. Chemicals
4.1.2. Microorganisms, Construction and Assembly of the RGB-S Reporter
4.2. Methods
4.2.1. Preparation of Glycolipid-Enriched Manuka Honey
4.2.2. Extraction and Detection of Glycolipids via Thin Layer Chromatography (TLC)
4.2.3. Susceptibility Test
4.2.4. Stress Assay Protocol
4.2.5. Assessment of Antibacterial Activity
5. Conclusions
Supplementary Materials
Author Contributions
Funding
Institutional Review Board Statement
Informed Consent Statement
Data Availability Statement
Acknowledgments
Conflicts of Interest
Abbreviations
| C. | Candida |
| C10 | Decanoic acid or ester |
| C12 | Lauric acid or ester |
| C14 | Myristic acid or ester |
| C16 | Palmitic acid or ester |
| C8 | Octanoic acid or ester |
| DES(s) | Deep Eutectic Solvent(s) |
| DNA | DeoxyriboNucleic Acid |
| E. | Escherichia |
| GDH | Glycolipid Decanoate Honey |
| GLH | Glycolipid Laurate Honey |
| GMH | Glycolipid Myristate Honey |
| GOH | Glycolipid Octanoate Honey |
| GPH | Glycolipid Palmitate Honey |
| Gram– | Gram negative |
| Gram+ | Gram positive |
| LB+kan | Luria-Bertani + kanamycin |
| MGO | MethylGlyOxal |
| MH | Manuka Honey |
| MHWE | Manuka Honey Without Enzyme |
| MRSA | Methicillin-Resistant Staphylococcus Aureus |
| OD600 | Optical Density at 600 nm |
| P. | Pseudomonas |
| Rf | Retention factor |
| RGB-S | Red Green Blue-Strain |
| Std | Standard |
| TLC | Thin Layer Chromatography |
References
- Jull, A.B.; Cullum, N.; Dumville, J.C.; Westby, M.J.; Deshpande, S.; Walker, N. Honey as a Topical Treatment for Wounds. Cochrane Database Syst. Rev. 2015, CD005083. [Google Scholar] [CrossRef] [PubMed]
- Dai, Y.; van Spronsen, J.; Witkamp, G.-J.; Verpoorte, R.; Choi, Y.H. Natural Deep Eutectic Solvents as New Potential Media for Green Technology. Anal. Chim. Acta 2013, 766, 61–68. [Google Scholar] [CrossRef] [PubMed]
- Durand, E.; Lecomte, J.; Villeneuve, P. From Green Chemistry to Nature: The Versatile Role of Low Transition Temperature Mixtures. Biochimie 2016, 120, 119–123. [Google Scholar] [CrossRef]
- Cooper, R.A.; Molan, P.C.; Harding, K.G. Antibacterial Activity of Honey against Strains of Staphylococcus Aureus from Infected Wounds. J. R. Soc. Med. 1999, 92, 283–285. [Google Scholar] [CrossRef] [PubMed]
- Weston, R.J.; Mitchell, K.R.; Allen, K.L. Antibacterial Phenolic Components of New Zealand Manuka Honey. Food Chem. 1999, 64, 295–301. [Google Scholar] [CrossRef]
- Simon, A.; Traynor, K.; Santos, K.; Blaser, G.; Bode, U.; Molan, P. Medical Honey for Wound Care—Still the ‘Latest Resort’? Evid. Based Complement. Altern. Med. 2009, 6, 165–173. [Google Scholar] [CrossRef]
- Mavric, E.; Wittmann, S.; Barth, G.; Henle, T. Identification and Quantification of Methylglyoxal as the Dominant Antibacterial Constituent of Manuka (Leptospermum scoparium) Honeys from New Zealand. Mol. Nutr. Food Res. 2008, 52, 483–489. [Google Scholar] [CrossRef]
- Arena, E.; Ballistreri, G.; Tomaselli, F.; Fallico, B. Survey of 1,2-Dicarbonyl Compounds in Commercial Honey of Different Floral Origin. J. Food Sci. 2011, 76, C1203–C1210. [Google Scholar] [CrossRef]
- Degen, J.; Hellwig, M.; Henle, T. 1,2-Dicarbonyl Compounds in Commonly Consumed Foods. J. Agric. Food Chem. 2012, 60, 7071–7079. [Google Scholar] [CrossRef]
- Kwakman, P.H.S.; Boer, L.; Ruyter-Spira, C.P.; Creemers-Molenaar, T.; Helsper, J.P.F.G.; Vandenbroucke-Grauls, C.M.J.E.; Zaat, S.A.J.; Velde, A.A. Medical-Grade Honey Enriched with Antimicrobial Peptides Has Enhanced Activity against Antibiotic-Resistant Pathogens. Eur. J. Clin. Microbiol. Infect. Dis. 2011, 30, 251–257. [Google Scholar] [CrossRef]
- Pöhnlein, M.; Ulrich, J.; Kirschhöfer, F.; Nusser, M.; Muhle-Goll, C.; Kannengiesser, B.; Brenner-Weiß, G.; Luy, B.; Liese, A.; Syldatk, C.; et al. Lipase-Catalyzed Synthesis of Glucose-6-O-Hexanoate in Deep Eutectic Solvents. Eur. J. Lipid Sci. Technol. 2015, 117, 161–166. [Google Scholar] [CrossRef]
- Siebenhaller, S.; Gentes, J.; Infantes, A.; Muhle-Goll, C.; Kirschhöfer, F.; Brenner-Weiß, G.; Ochsenreither, K.; Syldatk, C. Lipase-Catalyzed Synthesis of Sugar Esters in Honey and Agave Syrup. Front. Chem. 2018, 6, 24. [Google Scholar] [CrossRef] [PubMed]
- Bornscheuer, U.T.; Yamane, T. Fatty Acid Vinyl Esters as Acylating Agents: A New Method for the Enzymatic Synthesis of Monoacylglycerols. J. Am. Oil Chem. Soc. 1995, 72, 193–197. [Google Scholar] [CrossRef]
- Bornscheuer, U.; Herar, A.; Kreye, L.; Wendel, V.; Capewell, A.; Meyer, H.H.; Scheper, T.; Kolisis, F.N. Factors Affecting the Lipase Catalyzed Transesterification Reactions of 3-Hydroxy Esters in Organic Solvents. Tetrahedron Asymmetry 1993, 4, 1007–1016. [Google Scholar] [CrossRef]
- Lee, K.P.; Kim, H.K. Antibacterial Effect of Fructose Laurate Synthesized by Candida antarctica B Lipase-Mediated Transesterification. J. Microbiol. Biotechnol. 2016, 26, 1579–1585. [Google Scholar] [CrossRef]
- Siebenhaller, S.; Hajek, T.; Muhle-Goll, C.; Himmelsbach, M.; Luy, B.; Kirschhöfer, F.; Brenner-Weiß, G.; Hahn, T.; Zibek, S.; Syldatk, C. Beechwood Carbohydrates for Enzymatic Synthesis of Sustainable Glycolipids. Bioresour. Bioprocess. 2017, 4, 25. [Google Scholar] [CrossRef]
- Mandal, M.D.; Mandal, S. Honey: Its Medicinal Property and Antibacterial Activity. Asian Pac. J. Trop Biomed. 2011, 1, 154–160. [Google Scholar] [CrossRef]
- Molan, P.C.; Rhodes, T. Honey: A Biologic Wound Dressing. Wounds 2015, 27, 141–151. [Google Scholar]
- Ventola, C.L. The Antibiotic Resistance Crisis. Pharm. Ther. 2015, 40, 277–283. [Google Scholar]
- Wright, G. Antibiotics: An Irresistible Newcomer. Nature 2015, 517, 442–444. [Google Scholar] [CrossRef]
- Zoheir, A.E.; Sobol, M.S.; Ordonez-Rueda, D.; Kaster, A.-K.; Niemeyer, C.M.; Rabe, K.S. A Genetically-Encoded Three-Colour Stress Biosensor Reveals Multimodal Response at Single Cell Level and Spatiotemporal Dynamics of Biofilms. bioRxiv 2022. [Google Scholar] [CrossRef]
- Landini, P.; Egli, T.; Wolf, J.; Lacour, S. SigmaS, a Major Player in the Response to Environmental Stresses in Escherichia coli: Role, Regulation and Mechanisms of Promoter Recognition. Environ. Microbiol. Rep. 2014, 6, 1–13. [Google Scholar] [CrossRef] [PubMed]
- Arsène, F.; Tomoyasu, T.; Bukau, B. The Heat Shock Response of Escherichia Coli. Int. J. Food Microbiol. 2000, 55, 3–9. [Google Scholar] [CrossRef]
- Simmons, L.A.; Foti, J.J.; Cohen, S.E.; Walker, G.C. The SOS Regulatory Network. EcoSal Plus 2008, 3. [Google Scholar] [CrossRef] [PubMed]
- McCool, J.D.; Long, E.; Petrosino, J.F.; Sandler, H.A.; Rosenberg, S.M.; Sandler, S.J. Measurement of SOS Expression in Individual Escherichia Coli K-12 Cells Using Fluorescence Microscopy. Mol. Microbiol. 2004, 53, 1343–1357. [Google Scholar] [CrossRef] [PubMed]
- Lacour, S.; Landini, P. SigmaS-Dependent Gene Expression at the Onset of Stationary Phase in Escherichia coli: Function of SigmaS-Dependent Genes and Identification of Their Promoter Sequences. J. Bacteriol. 2004, 186, 7186–7195. [Google Scholar] [CrossRef]
- Van Dyk, T.K.; Smulski, D.R.; Reed, T.R.; Belkin, S.; Vollmer, A.C.; LaRossa, R.A. Responses to Toxicants of an Escherichia Coli Strain Carrying a UspA’::Lux Genetic Fusion and an E. Coli Strain Carrying a GrpE’::Lux Fusion Are Similar. Appl. Environ. Microbiol. 1995, 61, 4124–4127. [Google Scholar] [CrossRef]
- Campbell, R.E.; Tour, O.; Palmer, A.E.; Steinbach, P.A.; Baird, G.S.; Zacharias, D.A.; Tsien, R.Y. A Monomeric Red Fluorescent Protein. Proc. Natl. Acad. Sci. USA 2002, 99, 7877–7882. [Google Scholar] [CrossRef]
- Cormack, B.P.; Valdivia, R.H.; Falkow, S. FACS-Optimized Mutants of the Green Fluorescent Protein (GFP). Gene 1996, 173, 33–38. [Google Scholar] [CrossRef]
- Subach, O.M.; Cranfill, P.J.; Davidson, M.W.; Verkhusha, V.V. An Enhanced Monomeric Blue Fluorescent Protein with the High Chemical Stability of the Chromophore. PLoS ONE 2011, 6, e28674. [Google Scholar] [CrossRef]
- Russell, K.M.; Molan, P.C.; Wilkins, A.L.; Holland, P.T. Identification of Some Antibacterial Constituents of New Zealand Manuka Honey. J. Agric. Food Chem. 1990, 38, 10–13. [Google Scholar] [CrossRef]
- Allen, K.L.; Molan, P.C.; Reid, G.M. A Survey of the Antibacterial Activity of Some New Zealand Honeys. J. Pharm. Pharmacol. 1991, 43, 817–822. [Google Scholar] [CrossRef] [PubMed]
- Molan, P. Why Honey Is Effective as a Medicine. Bee World 2001, 82, 22–40. [Google Scholar] [CrossRef]
- Alvarez-Suarez, J.; Gasparrini, M.; Forbes-Hernández, T.; Mazzoni, L.; Giampieri, F. The Composition and Biological Activity of Honey: A Focus on Manuka Honey. Foods 2014, 3, 420–432. [Google Scholar] [CrossRef]
- Pätzold, M.; Siebenhaller, S.; Kara, S.; Liese, A.; Syldatk, C.; Holtmann, D. Deep Eutectic Solvents as Efficient Solvents in Biocatalysis. Trends Biotechnol. 2019, 37, 943–959. [Google Scholar] [CrossRef]
- Delavault, A.; Opochenska, O.; Laneque, L.; Soergel, H.; Muhle-Goll, C.; Ochsenreither, K.; Syldatk, C. Lipase-Catalyzed Production of Sorbitol Laurate in a “2-in-1” Deep Eutectic System: Factors Affecting the Synthesis and Scalability. Molecules 2021, 26, 2759. [Google Scholar] [CrossRef] [PubMed]
- Molan, P.C. The Antibacterial Activity of Honey. Bee World 1992, 73, 5–28. [Google Scholar] [CrossRef]
- Siebenhaller, S.; Grüninger, J.; Syldatk, C. Enzymatic Synthesis of Glycolipid Surfactants. In Lipid Modification by Enzymes and Engineered Microbes; Elsevier: Amsterdam, The Netherlands, 2018; pp. 293–313. ISBN 978-0-12-813167-1. [Google Scholar]
- Hollenbach, R.; Ochsenreither, K.; Syldatk, C. Enzymatic Synthesis of Glucose Monodecanoate in a Hydrophobic Deep Eutectic Solvent. Int. J. Mol. Sci. 2020, 21, 4342. [Google Scholar] [CrossRef]
- Brudzynski, K.; Abubaker, K.; Castle, A. Re-Examining the Role of Hydrogen Peroxide in Bacteriostatic and Bactericidal Activities of Honey. Front. Microbiol. 2011, 2, 213. [Google Scholar] [CrossRef]
- Adams, C.J.; Manley-Harris, M.; Molan, P.C. The Origin of Methylglyoxal in New Zealand Manuka (Leptospermum scoparium) Honey. Carbohydr. Res. 2009, 344, 1050–1053. [Google Scholar] [CrossRef]
- Grainger, M.N.C.; Manley-Harris, M.; Lane, J.R.; Field, R.J. Kinetics of Conversion of Dihydroxyacetone to Methylglyoxal in New Zealand Mānuka Honey: Part I—Honey Systems. Food Chem. 2016, 202, 484–491. [Google Scholar] [CrossRef] [PubMed]
- Willix, D.J.; Molan, P.C.; Harfoot, C.G. A Comparison of the Sensitivity of Wound-Infecting Species of Bacteria to the Antibacterial Activity of Manuka Honey and Other Honey. J. Appl. Bacteriol. 1992, 73, 388–394. [Google Scholar] [CrossRef] [PubMed]
- Shaburova, O.V.; Krylov, S.V.; Veiko, V.P.; Pleteneva, E.A.; Burkal’tseva, M.V.; Miroshnikov, K.A.; Cornelissen, A.; Lavigne, R.; Sykilinda, N.N.; Kadykov, V.A.; et al. Search for Destruction Factors of Bacterial Biofilms: Comparison of Phage Properties in a Group of Pseudomonas Putida Bacteriophages and Specificity of Their Halo-Formation Products. Russ. J. Genet. 2009, 45, 161–170. [Google Scholar] [CrossRef]
- Wagh, A.; Shen, S.; Shen, F.A.; Miller, C.D.; Walsh, M.K. Effect of Lactose Monolaurate on Pathogenic and Nonpathogenic Bacteria. Appl. Environ. Microbiol. 2012, 78, 3465–3468. [Google Scholar] [CrossRef] [PubMed]
- Kulakovskaya, T.V.; Shashkov, A.S.; Kulakovskaya, E.V.; Golubev, W.I. Characterization of an Antifungal Glycolipid Secreted by the Yeast Sympodiomycopsis Paphiopedili. FEMS Yeast Res. 2004, 5, 247–252. [Google Scholar] [CrossRef]
- Besada-Lombana, P.B.; Fernandez-Moya, R.; Fenster, J.; Da Silva, N.A. Engineering Saccharomyces Cerevisiae Fatty Acid Composition for Increased Tolerance to Octanoic Acid. Biotechnol. Bioeng. 2017, 114, 1531–1538. [Google Scholar] [CrossRef]
- Roelants, S.L.K.W.; Saerens, K.M.J.; Derycke, T.; Li, B.; Lin, Y.-C.; de Peer, Y.V.; Maeseneire, S.L.D.; Bogaert, I.N.A.V.; Soetaert, W. Candida Bombicola as a Platform Organism for the Production of Tailor-Made Biomolecules. Biotechnol. Bioeng. 2013, 110, 2494–2503. [Google Scholar] [CrossRef]
- Vakhlu, J. Yeast Lipases: Enzyme Purification, Biochemical Properties and Gene Cloning. Electron. J. Biotechnol. 2006, 9, 1. [Google Scholar] [CrossRef]
- Manolakaki, D.; Velmahos, G.; Kourkoumpetis, T.; Chang, Y.; Alam, H.B.; Moya, M.M.D.; Mylonakis, E. Candida Infection and Colonization among Trauma Patients. Virulence 2010, 1, 367–375. [Google Scholar] [CrossRef]
- Turner, S.A.; Butler, G. The Candida Pathogenic Species Complex. Cold Spring Harb. Perspect. Med. 2014, 4, a019778. [Google Scholar] [CrossRef]
- Donlan, R.M. Biofilm Formation: A Clinically Relevant Microbiological Process. Clin. Infect. Dis. 2001, 33, 1387–1392. [Google Scholar] [CrossRef] [PubMed]
- Altenbach, H.-J.; Ihizane, R.; Jakob, B.; Lange, K.; Schneider, M.; Yilmaz, Z.; Nandi, S. Synthesis and Characterization of Novel Surfactants: Combination Products of Fatty Acids, Hydroxycarboxylic Acids and Alcohols. J. Surfactants Deterg. 2010, 13, 399–407. [Google Scholar] [CrossRef]
- Ferrer, M.; Soliveri, J.; Plou, F.J.; López-Cortés, N.; Reyes-Duarte, D.; Christensen, M.; Copa-Patiño, J.L.; Ballesteros, A. Synthesis of Sugar Esters in Solvent Mixtures by Lipases from Thermomyces lanuginosus and Candida antarctica B, and Their Antimicrobial Properties. Enzym. Microb. Technol. 2005, 36, 391–398. [Google Scholar] [CrossRef]
- Dusane, D.H.; Rajput, J.K.; Kumar, A.R.; Nancharaiah, Y.V.; Venugopalan, V.P.; Zinjarde, S.S. Disruption of Fungal and Bacterial Biofilms by Lauroyl Glucose. Lett. Appl. Microbiol. 2008, 47, 374–379. [Google Scholar] [CrossRef] [PubMed]
- Razafindralambo, H.; Blecker, C.; Paquot, M. Carbohydrate-Based Surfactants: Structure-Activity Relationships. In Advances in Chemical Engineering; IntechOpen: London, UK, 2012. [Google Scholar] [CrossRef]
- Grüninger, J.; Delavault, A.; Ochsenreither, K. Enzymatic Glycolipid Surfactant Synthesis from Renewables. Process. Biochem. 2019, 87, 45–54. [Google Scholar] [CrossRef]
- Hollenbach, R.; Völp, A.R.; Höfert, L.; Rudat, J.; Ochsenreither, K.; Willenbacher, N.; Syldatk, C. Interfacial and Foaming Properties of Tailor-Made Glycolipids—Influence of the Hydrophilic Head Group and Functional Groups in the Hydrophobic Tail. Molecules 2020, 25, 3797. [Google Scholar] [CrossRef]
- Wise, R.; Hart, T.; Cars, O.; Streulens, M.; Helmuth, R.; Huovinen, P.; Sprenger, M. Antimicrobial Resistance. BMJ 1998, 317, 609–610. [Google Scholar] [CrossRef]
- Lambert, P.A. Bacterial Resistance to Antibiotics: Modified Target Sites. Adv. Drug Deliv. Rev. 2005, 57, 1471–1485. [Google Scholar] [CrossRef]
- Tenover, F.C. Mechanisms of Antimicrobial Resistance in Bacteria. Am. J. Med. 2006, 119, S3–S10. [Google Scholar] [CrossRef]
- Aroso, I.M.; Silva, J.C.; Mano, F.; Ferreira, A.S.D.; Dionísio, M.; Sá-Nogueira, I.; Barreiros, S.; Reis, R.L.; Paiva, A.; Duarte, A.R.C. Dissolution Enhancement of Active Pharmaceutical Ingredients by Therapeutic Deep Eutectic Systems. Eur. J. Pharm. Biopharm. 2016, 98, 57–66. [Google Scholar] [CrossRef]
- Radošević, K.; Ćurko, N.; Gaurina Srček, V.; Cvjetko Bubalo, M.; Tomašević, M.; Kovačević Ganić, K.; Radojčić Redovniković, I. Natural Deep Eutectic Solvents as Beneficial Extractants for Enhancement of Plant Extracts Bioactivity. LWT 2016, 73, 45–51. [Google Scholar] [CrossRef]
- Chen, J.; Wang, Q.; Liu, M.; Zhang, L. The Effect of Deep Eutectic Solvent on the Pharmacokinetics of Salvianolic Acid B in Rats and Its Acute Toxicity Test. J. Chromatogr. B 2017, 1063, 60–66. [Google Scholar] [CrossRef] [PubMed]
- Wikene, K.O.; Rukke, H.V.; Bruzell, E.; Tønnesen, H.H. Investigation of the Antimicrobial Effect of Natural Deep Eutectic Solvents (NADES) as Solvents in Antimicrobial Photodynamic Therapy. J. Photochem. Photobiol. B Biol. 2017, 171, 27–33. [Google Scholar] [CrossRef] [PubMed]
- Raab, D.; Graf, M.; Notka, F.; Schödl, T.; Wagner, R. The GeneOptimizer Algorithm: Using a Sliding Window Approach to Cope with the Vast Sequence Space in Multiparameter DNA Sequence Optimization. Syst. Synth. Biol. 2010, 4, 215–225. [Google Scholar] [CrossRef]
- Gibson, D.G.; Young, L.; Chuang, R.-Y.; Venter, J.C.; Hutchison, C.A.; Smith, H.O. Enzymatic Assembly of DNA Molecules up to Several Hundred Kilobases. Nat. Methods 2009, 6, 343–345. [Google Scholar] [CrossRef]
- Power, D.A.; Zimbro, M.J. Difco & BBL Manual: Manual of Microbiological Culture Media; Difco Laboratories, Division of Becton Dickinson and Co.: Sparks, MD, USA, 2003; ISBN 978-0-9727207-0-0. [Google Scholar]
- Patton, T.; Barrett, J.; Brennan, J.; Moran, N. Use of a Spectrophotometric Bioassay for Determination of Microbial Sensitivity to Manuka Honey. J. Microbiol. Methods 2006, 64, 84–95. [Google Scholar] [CrossRef]

| Microorganisms/Cell Type | MH | MHWE | GOH | GDH | GLH | GMH |
|---|---|---|---|---|---|---|
| MRSA/Gram+ | ++ | ++ | ++ | ++ | + | + |
| B. subtilis/Gram+ | +++ | +++ | +++ | +++ | +++ | +++ |
| C. bombicola/Yeast | 0 | 0 | +++ | + | 0 | 0 |
| E. coli/Gram– | ++ | ++ | +++ | +++ | +++ | +++ |
| P. putida/Gram– | + | + | ++ | + | + | + |
Publisher’s Note: MDPI stays neutral with regard to jurisdictional claims in published maps and institutional affiliations. |
© 2022 by the authors. Licensee MDPI, Basel, Switzerland. This article is an open access article distributed under the terms and conditions of the Creative Commons Attribution (CC BY) license (https://creativecommons.org/licenses/by/4.0/).
Share and Cite
Delavault, A.; Zoheir, A.E.; Muller, D.; Hollenbach, R.; Rabe, K.S.; Ochsenreither, K.; Rudat, J.; Syldatk, C. Enhanced Bioactivity of Tailor-Made Glycolipid Enriched Manuka Honey. Int. J. Mol. Sci. 2022, 23, 12031. https://doi.org/10.3390/ijms231912031
Delavault A, Zoheir AE, Muller D, Hollenbach R, Rabe KS, Ochsenreither K, Rudat J, Syldatk C. Enhanced Bioactivity of Tailor-Made Glycolipid Enriched Manuka Honey. International Journal of Molecular Sciences. 2022; 23(19):12031. https://doi.org/10.3390/ijms231912031
Chicago/Turabian StyleDelavault, André, Ahmed E. Zoheir, Delphine Muller, Rebecca Hollenbach, Kersten S. Rabe, Katrin Ochsenreither, Jens Rudat, and Christoph Syldatk. 2022. "Enhanced Bioactivity of Tailor-Made Glycolipid Enriched Manuka Honey" International Journal of Molecular Sciences 23, no. 19: 12031. https://doi.org/10.3390/ijms231912031
APA StyleDelavault, A., Zoheir, A. E., Muller, D., Hollenbach, R., Rabe, K. S., Ochsenreither, K., Rudat, J., & Syldatk, C. (2022). Enhanced Bioactivity of Tailor-Made Glycolipid Enriched Manuka Honey. International Journal of Molecular Sciences, 23(19), 12031. https://doi.org/10.3390/ijms231912031

